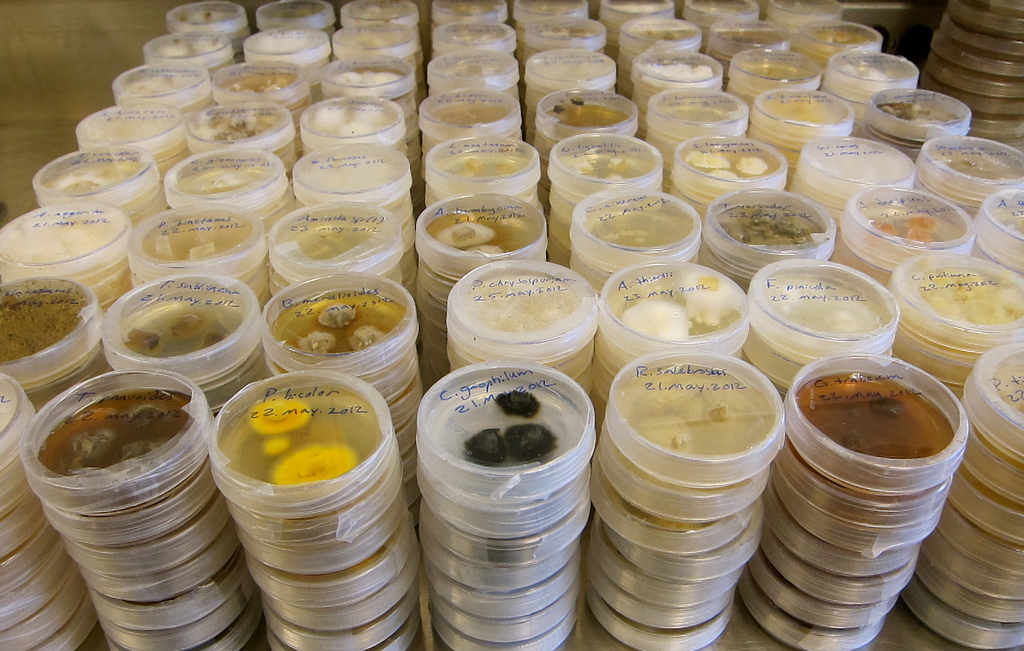
Workshop FELACC 2021

Workshop FELACC 2021
Workshop FELACC 2021 Estamos muy felices de invitarles al Workshop FELACC – Preservación ex situ y Gestión de Datos en Colecciones de Cultivos Microbianos, organizado por la FELACC-Federación Latinoamericana de Colecciones de Cultivos en colaboración con la...
3er Seminario Internacional de Agricultura Orgánica
3er Seminario Internacional de Agricultura Orgánica Los próximos 17 y 18 de Noviembre de 2020 se desarrollará el “3er Seminario Internacional de Agricultura Orgánica, Chile 2020”, desde la Región de la Araucanía. Un evento que tendrá por objetivo la transferencia de...
BioControl LATAM – 2020
BioControl LATAM – 2020 La Conferencia y Exhibición de BioControl LATAM se realizará en Santiago de Chile, entre el 24 y 28 de Agosto, con el auspicio de New Ag International, con el apoyo de IBMA y 2BMonthly. La Red Chilena de Bioinsumos estará participando...
Asamblea de Socios – Junio 2019
Este pasado 13 de Junio de 2019 se realizó la primera asamblea de la Red Chilena de Bioinsumos A.G. El programa desarrollado fue segmentado en 2 bloques: Contenidos AM 1.- Presentación de Directorio 2.- Historia, rendición de cuentas, funcionamiento y participaciones...
